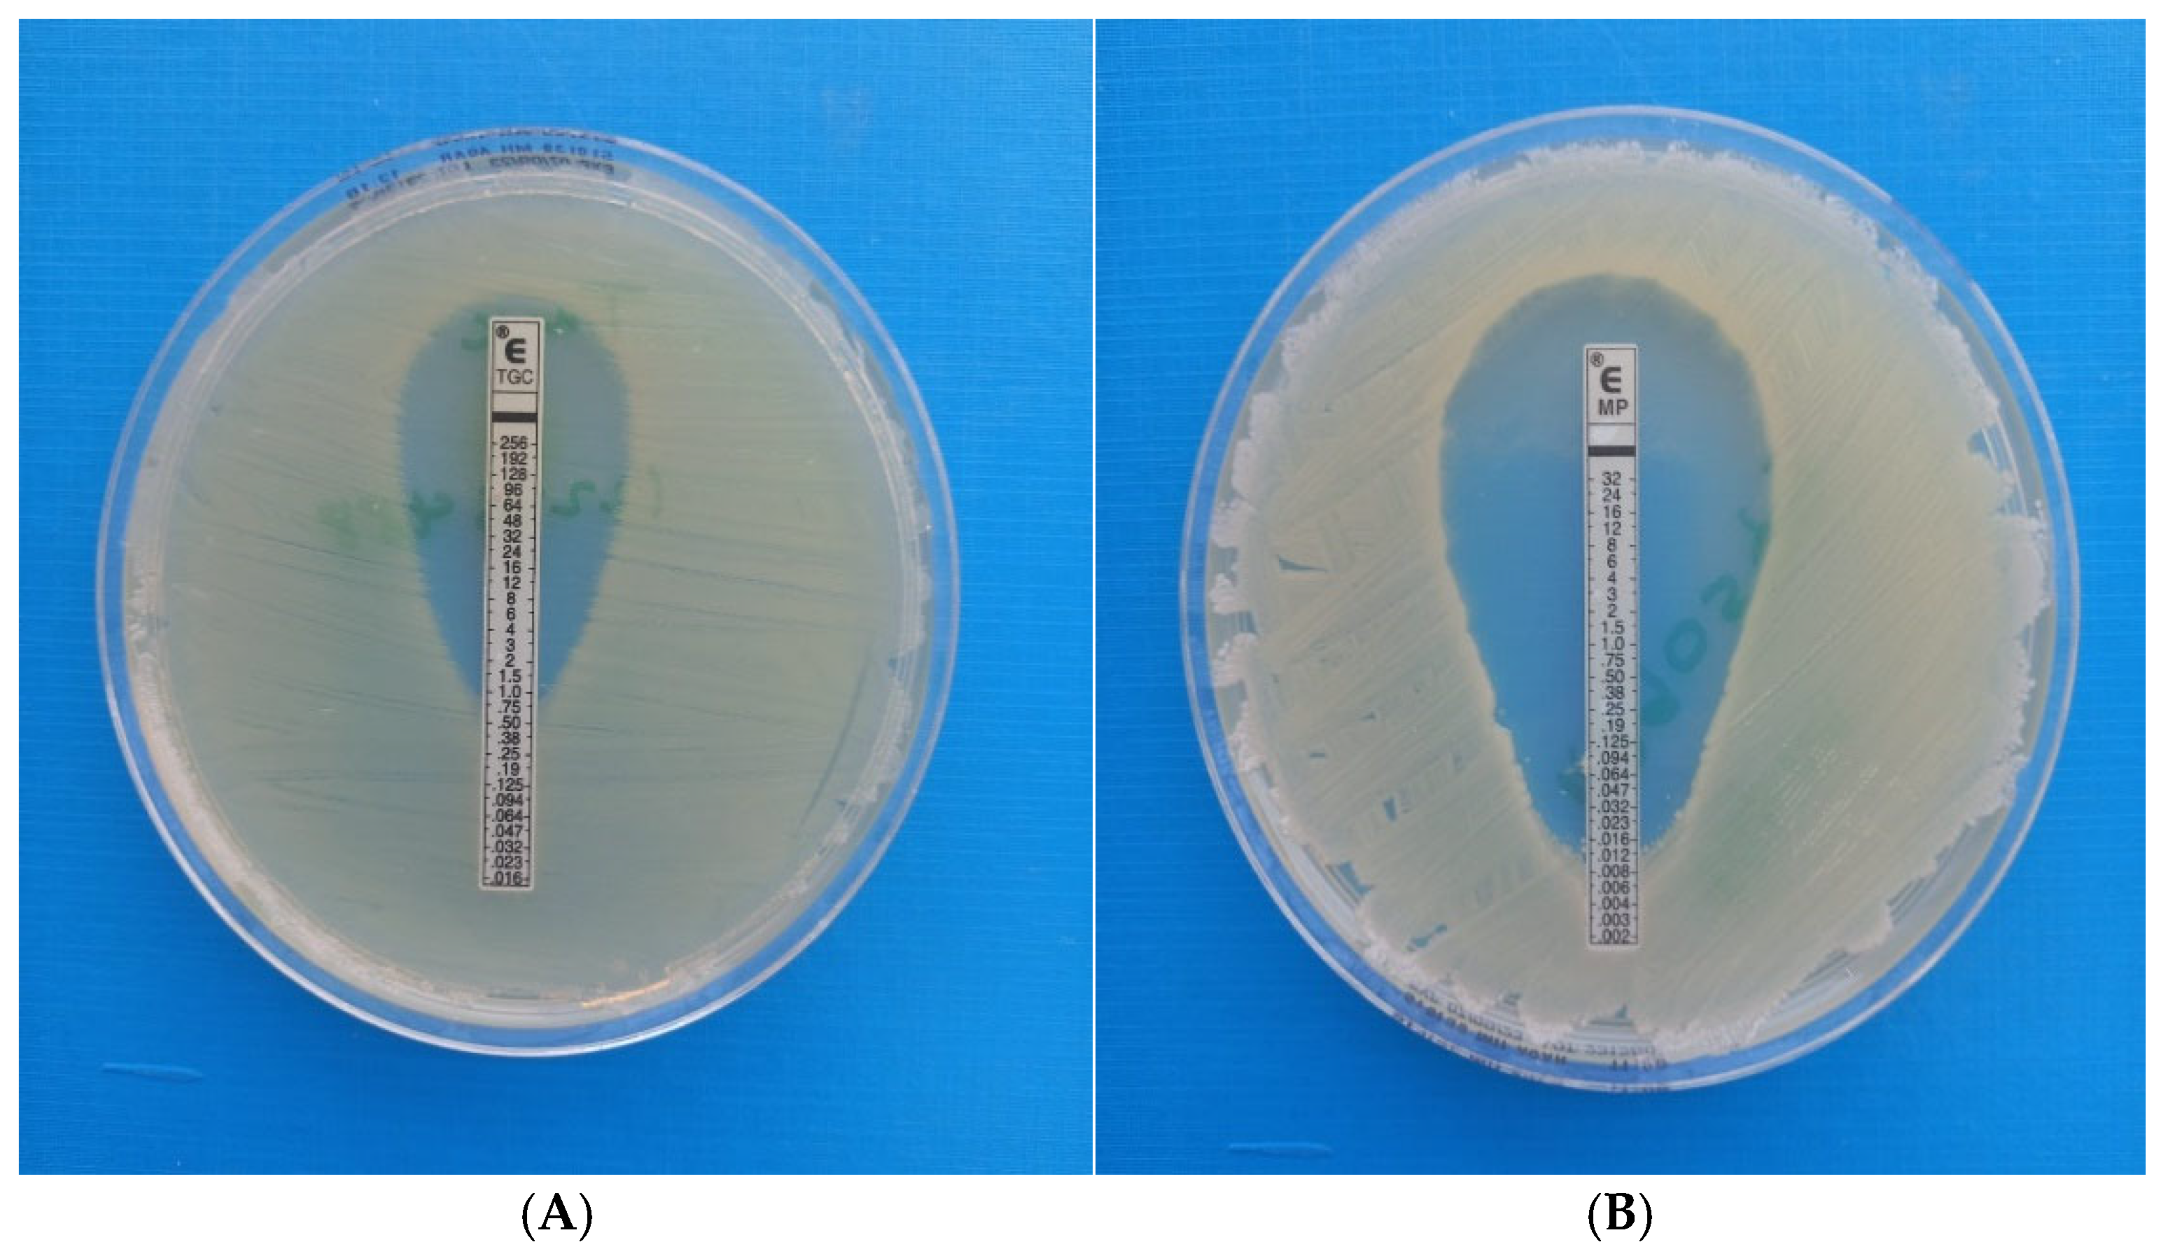
Antibiotics 14 00630 g003
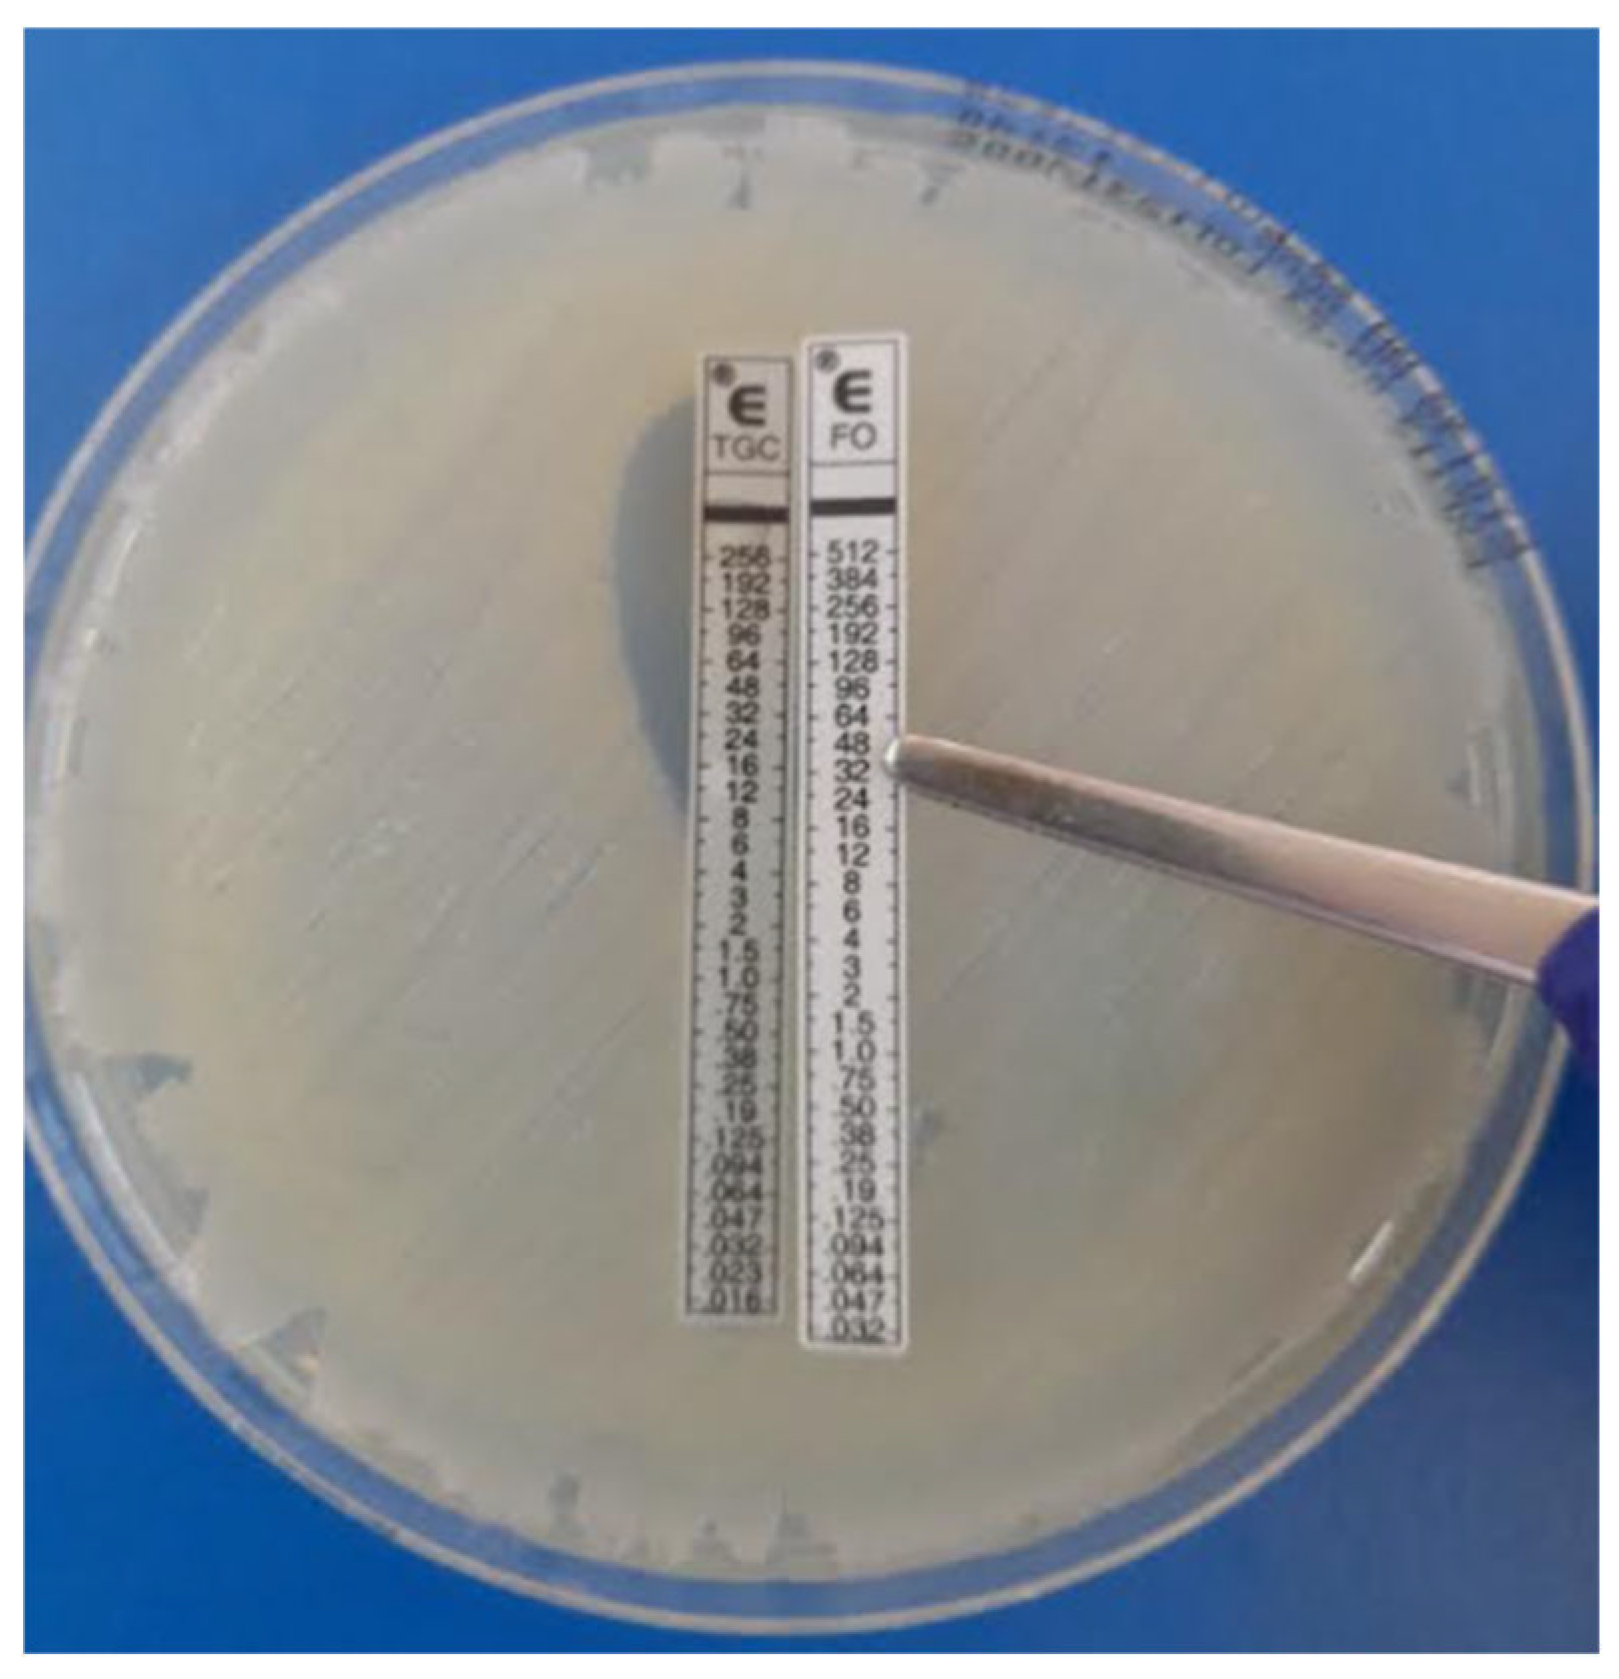
Antibiotics 14 00630 g005

In Vitro Evaluation of Antimicrobial Synergy Against Multidrug-Resistant Gram-Negative Paediatric Bloodstream Pathogens in South Africa
Abstract
1. Introduction
2. Results
2.1. MIC Distribution and Disk Diffusion Susceptibility Testing of Study Isolates
2.1.1. Types of MDR GN Isolates Studied
2.1.2. Susceptibility of MDR GN Isolates Against Individual Antibiotics
2.1.3. Comparison of Colistin and Meropenem
2.1.4. Comparison of Colistin and Tigecycline
2.1.5. Comparison of Fosfomycin and Colistin
2.1.6. Comparison of Tigecycline and Fosfomycin
2.1.7. Comparison of Tigecycline and Meropenem
2.1.8. Comparison of Fosfomycin and Meropenem


3. Ethical Considerations
4. Discussion
5. Materials and Methods
5.1. Study Design and Population
5.2. Study Setting
5.2.1. Laboratory Processing of Blood Culture Specimens
5.2.2. Carbapenemase Determination in CRE
5.3. Study Procedures
5.3.1. Meropenem, Tigecycline and Fosfomycin MIC Determination
5.3.2. Colistin Broth Microdilution (BMD) Determination of MIC
5.3.3. E-Test Synergy Testing (Fixed-Ratio) Methodology (AB Biodisk, Solna, Sweden)
6. Conclusions
Author Contributions
Funding
Institutional Review Board Statement
Informed Consent Statement
Data Availability Statement
Acknowledgments
Conflicts of Interest
Abbreviations
| multidrug-resistant | MDR |
| Gram-negative | GN |
| Gram-negative bacteria | GNB |
| species | spp. |
| antimicrobial resistance | AMR |
| carbapenem-resistant organisms | CROs |
| time-kill assays | TKA |
| Synergy testing | ST |
| Checkerboard Assays | CA |
| Epsilometer test | E-test |
| fractional inhibitory concentration | FIC |
| carbapenem-resistant Enterobacterales | CRE |
| extremely drug-resistant | XDR |
| low and middle-income countries | LMIC |
| bloodstream | BS |
| Bloodstream infections | BSI |
| Chris Hani Baragwanath Academic Hospital | CHBAH |
| National Health Laboratory Service | NHLS |
| standard operating procedures | SOPs |
| Antimicrobial susceptibility testing | AST |
| Clinical Laboratory Standards Institute | CLSI |
| Kirby Bauer disk diffusion | KBDD |
| oxacillinase | OXA-48 |
| Klebsiella pneumoniae carbapenemase | KPC |
| New Delhi metallo-beta-lactamase | NDM |
| Verona integron metallo-beta-lactamase | VIM |
| Imipenemase | IMP |
| Minimum inhibitory concentrations | MICs |
| Food and Drug Association | FDA |
| European Committee on Antimicrobial Susceptibility Testing | EUCAST |
| Broth microdilution | BMD |
| Mueller Hinton | MH |
References
- Romandini, A.; Pani, A.; Schenardi, P.A.; Angela, G.; Pattarino, C.; De Giacomo, C.; Scaglione, F. Antibiotic Resistance in Pediatric Infections: Global Emerging Threats, Predicting the Near Future. Antibiotics 2021, 10, 393. [Google Scholar] [CrossRef] [PubMed]
- Aguilera-Alonso, D.; Escosa-García, L.; Saavedra-Lozano, J.; Cercenado, E.; Baquero-Artigao, F. Carbapenem-resistant Gram-negative bacterial infections in children. Antimicrob. Agents Chemother. 2020, 64, e02183-19. [Google Scholar] [CrossRef] [PubMed]
- Gaudereto, J.J.; Neto, L.V.P.; Leite, G.C.; Espinoza, E.P.S.; Martins, R.C.R.; Villas Boa Prado, G.; Rossi, F.; Guimarães, T.; Levin, A.S.; Costa, S.F. Comparison of methods for the detection of in vitro synergy in multidrug-resistant gram-negative bacteria. BMC Microbiol. 2020, 20, 97. [Google Scholar] [CrossRef] [PubMed]
- Mantzana, P.; Protonotariou, E.; Kassomenaki, A.; Meletis, G.; Tychala, A.; Keskilidou, E.; Arhonti, M.; Katsanou, C.; Daviti, A.; Vasilaki, O.; et al. In Vitro Synergistic Activity of Antimicrobial Combinations against Carbapenem- and Colistin-Resistant Acinetobacter baumannii and Klebsiella pneumoniae. Antibiotics 2023, 12, 93. [Google Scholar] [CrossRef]
- Alshareef, F.; Review, B. Protocol to Evaluate Antibacterial Activity MIC, FIC and Time Kill Method. Acta Sci. Microbiol. 2021, 4, 2–6. [Google Scholar] [CrossRef]
- Laishram, S.; Pragasam, A.; Bakthavatchalam, Y.; Veeraraghavan, B. An update on technical, interpretative and clinical relevance of antimicrobial synergy testing methodologies. Indian J. Med. Microbiol. 2017, 35, 445–468. [Google Scholar] [CrossRef]
- Doern, C.D. When does 2 plus 2 equal 5? A review of antimicrobial synergy testing. J. Clin. Microbiol. 2014, 9, 4124–4128. [Google Scholar] [CrossRef]
- Byun, J.H.; Park, S.E.; Seo, M.; Jang, J.; Hwang, M.S.; Song, J.Y.; Chang, C.L.; Kim, Y.A. Controlling an Outbreak of Multidrug-resistant Acinetobacter baumannii in a Pediatric Intensive Care Unit: A Retrospective Analysis. J. Korean Med. Sci. 2021, 36, e307. [Google Scholar] [CrossRef]
- Reddy, K.; Bekker, A.; Whitelaw, A.C.; Esterhuizen, T.M.; Dramowski, A. A retrospective analysis of pathogen profile, antimicrobial resistance and mortality in neonatal hospital-acquired bloodstream infections from 2009–2018 at Tygerberg Hospital, South Africa. PLoS ONE 2021, 16, e0245089. [Google Scholar] [CrossRef]
- Thomas, R.; Wadula, J.; Seetharam, S.; Velaphi, S. Prevalence, antimicrobial susceptibility profiles and case fatality rates of acinetobacter baumannii sepsis in a neonatal unit. J. Infect. Dev. Ctries. 2018, 12, 211–219. [Google Scholar] [CrossRef]
- Sirijatuphat, R.; Thamlikitkul, V. Preliminary study of colistin versus colistin plus fosfomycin for treatment of carbapenem-resistant Acinetobacter baumannii infections. Antimicrob. Agents Chemother. 2014, 58, 5598–5601. [Google Scholar] [CrossRef] [PubMed]
- Williams, P.C.M. Potential of fosfomycin in treating multidrug-resistant infections in children. J. Paediatr. Child Health 2020, 56, 864–872. [Google Scholar] [CrossRef] [PubMed]
- Satlin, M.J.; Lewis, J.S.; Weinstein, M.P.; Patel, J.; Humphries, R.M.; Kahlmeter, G.; Giske, C.G.; Turnidge, J. Clinical and Laboratory Standards Institute and European Committee on Antimicrobial Susceptibility Testing Position Statements on Polymyxin B and Colistin Clinical Breakpoints. Clin. Infect. Dis. Off. Publ. Infect. Dis. Soc. Am. 2020, 24, 865–870. [Google Scholar] [CrossRef] [PubMed]
- CLSI working group. Clinical and Laboratory Standards Institute (CLSI)—M100. In Lexikon der Medizinischen Laboratoriumsdiagnostik; Springer Reference Medizin; Gressner, A.M., Arndt, T., Eds.; Springer: Berlin/Heidelberg, Germany, 2024. [Google Scholar] [CrossRef]
- EUCAST Scientific Committee. EUCAST General Consultation on Fosfomycin IV Breakpoints; EUCAST: Växjö, Sweden, 2022. [Google Scholar]
- Abdul-Mutakabbir, J.C.; Yim, J.; Nguyen, L.; Maassen, P.T.; Stamper, K.; Shiekh, Z.; Kebriaei, R.; Shields, R.K.; Castanheira, M.; Kaye, K.S.; et al. In vitro synergy of colistin in combination with meropenem or tigecycline against carbapenem-resistant Acinetobacter baumannii. Antibiotics 2021, 10, 880. [Google Scholar] [CrossRef]
- Zusman, O.; Avni, T.; Leibovici, L.; Adler, A.; Friberg, L.; Stergiopoulou, T.; Carmeli, Y.; Paul, M. Systematic review and meta-analysis of in vitro synergy of polymyxins and carbapenems. Antimicrob. Agents Chemother. 2013, 57, 5104–5111. [Google Scholar] [CrossRef]
- Gauba, A.; Rahman, K.M. Evaluation of Antibiotic Resistance Mechanisms in Gram-Negative Bacteria. Antibiotics 2023, 12, 1590. [Google Scholar] [CrossRef]
- Binsker, U.; Käsbohrer, A.; Hammerl, J.A. Global colistin use: A review of the emergence of resistant Enterobacterales and the impact on their genetic basis. FEMS Microbiol. Rev. 2022, 46, fuab049. [Google Scholar] [CrossRef]
- Durante-Mangoni, E.; Andini, R.; Zampino, R. Management of carbapenem-resistant Enterobacteriaceae infections. Clin. Microbiol. Infect. 2019, 8, 943–950. [Google Scholar] [CrossRef]
- Goel, A.; Gupta, V.; Singhal, L.; Palta, S.; Chander, J. In vitro evaluation of antibiotic synergy for carbapenem-resistant Klebsiella pneumoniae clinical isolates. Indian J. Med. Res. 2021, 154, 520–526. [Google Scholar] [CrossRef]
- Ni, W.; Yang, D.; Guan, J.; Xi, W.; Zhou, D.; Zhao, L.; Cui, J.; Xu, Y.; Gao, Z.; Liu, Y. In vitro and in vivo synergistic effects of tigecycline combined with aminoglycosides on carbapenem-resistant Klebsiella pneumoniae. J. Antimicrob. Chemother. 2021, 76, 2097–2105. [Google Scholar] [CrossRef]
- Ku, Y.H.; Chen, C.C.; Lee, M.F.; Chuang, Y.C.; Tang, H.J.; Yu, W.L. Comparison of synergism between colistin, fosfomycin and tigecycline against extended-spectrum β-lactamase-producing Klebsiella pneumoniae isolates or with carbapenem resistance. J. Microbiol. Immunol. Infect. 2017, 50, 931–939. [Google Scholar] [CrossRef] [PubMed]
- Parveen, L.; Khan, F.; Shah, S.; Nadeem, A.; Sultan, A.; Khan, A.U. Invitro Antimicrobial Synergy of Carbapenem with Tigecycline and Colistin in Gram negative isolates from ICU. Int. J. Hum. Health Sci. 2021, S198–S210. [Google Scholar] [CrossRef]
- Sharland, M.; Rodvold, K.A.; Tucker, H.R.; Baillon-Plot, N.; Tawadrous, M.; Hickman, M.A.; Raber, S.; Korth-Bradley, J.M.; Díaz-Ponce, H.; Wible, M. Safety and Efficacy of Tigecycline to Treat Multidrug-resistant Infections in Pediatrics: An Evidence Synthesis. Pediatr. Infect. Dis. J. 2019, 38, 710–715. [Google Scholar] [CrossRef] [PubMed]
- Ipek, M.S.; Gunel, M.E.; Ozbek, E.; Satlina, M.J.; Hsu, A.J.; Tamma, P.D.; Kaufman, J.; Temple-Smith, M.; Sanci, L. The search for a practical method for colistin susceptibility testing: Have we found it by going back to the future? J. Clin. Microbiol. 2019, 14, 103–107. [Google Scholar] [CrossRef]
- Dijkmans, A.C.; Zacarías, N.V.O.; Burggraaf, J.; Mouton, J.W.; Wilms, E.B.; van Nieuwkoop, C.; Touw, D.J.; Stevens, J.; Kamerling, I.M.C. Fosfomycin: Pharmacological, clinical and future perspectives. Antibiotics 2017, 6, 24. [Google Scholar] [CrossRef]
- Nwabor, O.F.; Terbtothakun, P.; Voravuthikunchai, S.P.; Chusri, S. Evaluation of the synergistic antibacterial effects of fosfomycin in combination with selected antibiotics against carbapenem–resistant Acinetobacter baumannii. Pharmaceuticals 2021, 14, 185. [Google Scholar] [CrossRef]
- da Silva Ribeiro, A.C.; Chikhani, Y.C.d.S.A.; Valiatti, T.B.; Valêncio, A.; Kurihara, M.N.L.; Santos, F.F.; Minarini, L.A.d.R.; Gales, A.C. In vitro and in vivo synergism of fosfomycin in combination with meropenem or polymyxin B against KPC-2-producing Klebsiella pneumoniae clinical isolates. Antibiotics 2023, 12, 237. [Google Scholar] [CrossRef]
- Magiorakos, A.P.; Srinivasan, A.; Carey, R.B.; Carmeli, Y.; Falagas, M.E.; Giske, C.G.; Harbarth, S.; Hindler, J.F.; Kahlmeter, G.; Olsson-Liljequist, B.; et al. Multidrug-resistant, extensively drug-resistant and pandrug-resistant bacteria: An international expert proposal for interim standard definitions for acquired resistance. Clin. Microbiol. Infect. 2012, 18, 268–281. [Google Scholar] [CrossRef]
- Thermo Scientific. Thermo Scientific Sensititre Plate Guide for Antimicrobial Susceptibility Testing. 2018. Available online: http://www.who.int/mediacentre/news/releases/2017/running-out-antibiotics/en/ (accessed on 12 June 2025).

| Carbapenem-Resistant Klebsiella pneumoniae (n = 35) | ||||||||||
|---|---|---|---|---|---|---|---|---|---|---|
| Antimicrobial MIC (µg/mL) | ≤1 | 2 | 4 | 6 | 8 | 16 | 24 | 32 | ||
| Meropenem | 8 | 2 | 3 | 2 | 2 | 6 | 0 | 12 | ||
| Tigecycline | 2 | 29 | 2 | 1 | 1 | 0 | 0 | 0 | ||
| Colistin | 32 | 3 | 0 | 0 | 0 | 0 | 0 | 0 | ||
| Antimicrobial MIC (µg/mL) | ≤8 | 16 | 32 | 64 | 96 | 128 | 192 | 256 | 384 | 512 |
| Fosfomycin | 5 | 3 | 8 | 4 | 2 | 4 | 2 | 1 | 0 | 6 |
| Carbapenem-Resistant E. coli (n = 3) | ||||||||||
| Antimicrobial MIC (µg/mL) | ≤1 | 2 | 4 | 6 | 8 | 16 | 24 | 32 | ||
| Meropenem | 1 | 1 | 0 | 0 | 0 | 0 | 0 | 1 | ||
| Tigecycline | 1 | 2 | 0 | 0 | 0 | 0 | 0 | 0 | ||
| Colistin | 2 | 1 | 0 | 0 | 0 | 0 | 0 | 0 | ||
| Antimicrobial MIC (µg/mL) | ≤8 | 16 | 32 | 64 | 96 | 128 | 192 | 256 | 384 | 512 |
| Fosfomycin | 0 | 1 | 2 | 0 | 0 | 0 | 0 | 0 | 0 | 0 |
| XDR Acinetobacter Species (n = 30) | ||||||||||
|---|---|---|---|---|---|---|---|---|---|---|
| Antimicrobial MIC (µg/mL) | ≤1 | 2 | 4 | 6 | 8 | 16 | 24 | 32 | ||
| Meropenem | 0 | 0 | 0 | 0 | 0 | 0 | 0 | 30 | ||
| Tigecycline | 2 | 27 | 1 | 0 | 0 | 0 | 0 | 0 | ||
| Colistin | 25 | 5 | 0 | 0 | 0 | 0 | 0 | 0 | ||
| Antimicrobial MIC (µg/mL) | ≤8 | 16 | 32 | 64 | 96 | 128 | 192 | 256 | 384 | 512 |
| Fosfomycin | 1 | 1 | 2 | 1 | 1 | 0 | 1 | 1 | 0 | 22 |
| Interpretation of FIC Index = MICAB/MICA + MICBA/MICB | Definition | |
|---|---|---|
| Synergy | ≤0.5 | Describes the combination of antibiotics that produces an effect more potent than the combined potencies of each antibiotic. |
| Additive | >0.5 and ≤1.0 | Denotes the effect of the drug combination being equal to the sum of the effects of each drug |
| Indifference | >1 and ≤4.0 | Expressed when the drug combination is equal to the effect of the most active drug |
| Antagonism | >4.0 | Describes the potency of the combination is less than the combined potencies of each antibiotic |
Disclaimer/Publisher’s Note: The statements, opinions and data contained in all publications are solely those of the individual author(s) and contributor(s) and not of MDPI and/or the editor(s). MDPI and/or the editor(s) disclaim responsibility for any injury to people or property resulting from any ideas, methods, instructions or products referred to in the content. |
© 2025 by the authors. Licensee MDPI, Basel, Switzerland. This article is an open access article distributed under the terms and conditions of the Creative Commons Attribution (CC BY) license (https://creativecommons.org/licenses/by/4.0/).
Share and Cite
Jaglal, P.; Velaphi, S.C.; Menezes, C.N.; Swe Swe-Han, K. In Vitro Evaluation of Antimicrobial Synergy Against Multidrug-Resistant Gram-Negative Paediatric Bloodstream Pathogens in South Africa. Antibiotics 2025, 14, 630. https://doi.org/10.3390/antibiotics14070630
Jaglal P, Velaphi SC, Menezes CN, Swe Swe-Han K. In Vitro Evaluation of Antimicrobial Synergy Against Multidrug-Resistant Gram-Negative Paediatric Bloodstream Pathogens in South Africa. Antibiotics. 2025; 14(7):630. https://doi.org/10.3390/antibiotics14070630
Chicago/Turabian StyleJaglal, Prenika, Sithembiso Christopher Velaphi, Colin Nigel Menezes, and Khine Swe Swe-Han. 2025. "In Vitro Evaluation of Antimicrobial Synergy Against Multidrug-Resistant Gram-Negative Paediatric Bloodstream Pathogens in South Africa" Antibiotics 14, no. 7: 630. https://doi.org/10.3390/antibiotics14070630
APA StyleJaglal, P., Velaphi, S. C., Menezes, C. N., & Swe Swe-Han, K. (2025). In Vitro Evaluation of Antimicrobial Synergy Against Multidrug-Resistant Gram-Negative Paediatric Bloodstream Pathogens in South Africa. Antibiotics, 14(7), 630. https://doi.org/10.3390/antibiotics14070630







